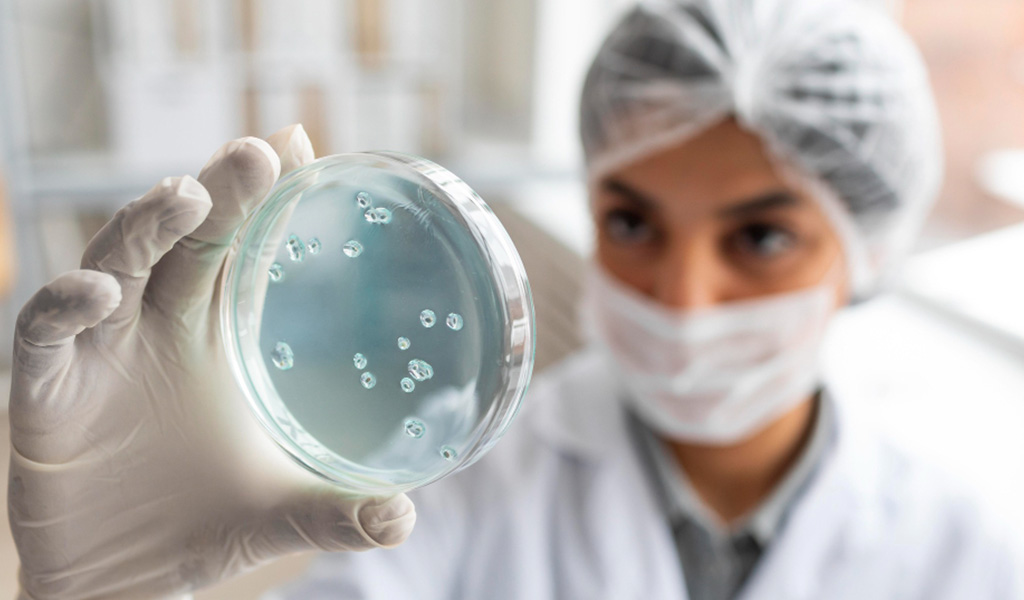
Blastocyst Culture

Blastocyst Culture Treatment in Noida
Book an AppointmentWhat is Blastocyst Culture Treatment?
Blastocyst culture means letting the embryo grow for 5 or 6 days after fertilization. It’s part of IVF. Not every embryo gets that far. So, waiting shows which ones are stronger. That helps doctors pick the best one for transfer. It’s a bit like giving them a test—only the good ones pass. The goal? Better chances of pregnancy. At SCI IVF, this step happens inside a safe lab. Conditions are steady—no sudden changes. Embryos grow in peace. It’s a careful job. Small things matter a lot. One strong embryo can make all the difference.
Book An Appointment
Blastocyst Embryo Transfer Treatments at SCI IVF Noida
SCI IVF doesn’t rush embryo transfer. They let it reach the blastocyst stage first. That takes 5 days or more. Their lab keeps temperature, air, and light just right. It feels like the womb. Embryos grow better that way. Doctors use soft tools, so transfer isn’t painful. They match the timing with your body’s signals—no guesswork. Every move is planned. Their team watches the embryo closely and chooses the one that’s doing best. That’s why people trust them. If you’re thinking of blastocyst culture IVF in Noida, SCI IVF knows what they’re doing.

Important Lab Tests Before Treatment
For Men
For women, tests are done to check hormone levels—FSH, LH, AMH, and thyroid. An ultrasound may be done to assess the uterus and ovarian reserve. If needed, doctors will ask for HSG (to check if the tubes are open). Blood sugar, infection markers, and vitamin levels may also be tested.
For Women (if required for IVF/ICSI)
For men, semen analysis is usually enough. It looks at count, motility, and shape. If sperm is low or absent, hormone tests like testosterone or prolactin may be added. If needed, DNA fragmentation tests are done too. But not everyone needs every test. The clinic checks history first, then suggests what's needed.
What to Expect?
During the Process
The process starts after eggs are retrieved and fertilized in the lab. Instead of transferring the embryo on Day 2 or 3, doctors let it grow until Day 5 or 6. The embryo is watched every day. Once it becomes a blastocyst, the embryologist picks the best one for transfer. The actual transfer is quick, usually less than 10 minutes. No anesthesia is needed. A thin tube is used to place the embryo gently into the uterus. After this, you can go home the same day. Some women are given progesterone to support the uterus after the transfer.
After the Process
There’s no strict bed rest after transfer. Most women return to normal activities in a day or two. Some may feel light cramping or minor spotting, but it's nothing serious. Doctors usually advise avoiding heavy lifting and stressful workouts for a few days. You may be prescribed hormonal medicines to help support implantation. The waiting period is about 10 to 14 days before a pregnancy test. That time can feel slow, with lots of hope and nerves.
Success Rate of Blastocyst Culture Treatment in Noida
Success rates with blastocyst transfer are usually higher than earlier-stage embryo transfers. At SCI IVF, success depends on age, egg quality, and overall health, but generally More than 70%. For women under 35, chances are even better. Since only healthy, developed embryos are selected, outcomes are more predictable.
Cost of Blastocyst Culture Treatment in Noida
The blastocyst culture IVF cost in Noida at SCI IVF starts from ₹70,000 to ₹1,20,000, depending on your treatment plan. This includes egg retrieval, lab culture, embryo development till Day 5 or 6, and the transfer. Hormonal injections, blood tests, and freezing (if needed) may cost extra. No hidden charges.
Step-by-Step Procedure
- Ovarian stimulation: You’ll be given hormone injections for around 10–12 days to help your ovaries grow more eggs than usual.
- Monitoring: During this time, you’ll have a few scans and blood tests to track how the follicles are growing.
- Egg retrieval: Once the eggs are ready, they’re taken out through a small procedure done under mild anesthesia.
- Fertilization: The eggs are combined with sperm in the lab. If needed, ICSI is used (where a single sperm is injected into the egg).
- Blastocyst culture: Instead of transferring early embryos (Day 2 or 3), the embryos are kept in special culture media for up to 5–6 days. Only the ones that continue to grow and reach the blastocyst stage are chosen.
- Embryo selection: Embryologists check how well the embryos have developed. The best ones are picked for transfer.
- Embryo transfer: One or two blastocysts are gently placed into the uterus using a soft catheter. No cuts, no pain.
- Support medication: You’ll be given progesterone or other hormones to support implantation.
- Pregnancy test: 10 to 14 days later, a blood test will confirm if the embryo has implanted successfully.

Benefits of Blastocyst Culture Treatment
- Helps choose stronger embryos for transfer
- Higher implantation rate than early-stage transfers
- Lowers the risk of multiple pregnancies
- Good option for women with previous IVF failure
- Embryo quality can be better assessed
- Reduces the chances of miscarriage in many cases
- Can be combined with PGT (genetic testing)
- Mimics the natural timing of implantation
- Often, fewer embryos are needed
- Helps avoid transferring weak or non-viable embryos
What is the Age Limit for Treatment?
Blastocyst culture works best for women under 40. Beyond that, egg quality usually starts to drop, and chances go down. At SCI IVF, women up to 50 may still try, especially if donor eggs are being used. Doctors will always evaluate your health first before suggesting the right plan.
Why Do People Choose Blastocyst Culture Treatment?
Many couples pick blastocyst culture because it improves their chance of success without adding risk. For those who’ve had failed IVF in the past, it gives the embryo a better shot at developing properly before transfer. It’s also preferred when embryo quality is uncertain, or when couples want to avoid twins or triplets. Doctors get more time to watch the embryo grow and select the healthiest one. The process also matches the uterus’s natural timing more closely, which helps with implantation.
What Do You Do to Prepare for Blastocyst Culture Treatment?
- Start taking folic acid or prenatal vitamins early
- Quit smoking, drinking, and caffeine-heavy drinks
- Eat balanced meals; cut down junk food
- Tell your doctor about any medicines you’re on
- Stay active but avoid intense workouts
- Reduce stress—consider yoga, journaling, or light walks
- Get all recommended blood tests done before starting
What are the Results After the Procedure?
- Mild cramping or bloating is common
- You may have some spotting—don’t worry
- Fatigue and mood changes might happen
- No need for complete bed rest
- Avoid sexual activity for 3–5 days
- Wait 10–14 days for your pregnancy test
- Take all medicines exactly as told
- Some women feel emotional during this time
- Eat home-cooked food, avoid processed stuff
- Don’t lift anything heavy
- Avoid long travel or standing for hours
- Call the clinic if anything feels off
Why Choose SCI IVF for Blastocyst Culture in Noida?
- Experienced doctors who explain every step
- Clean, well-maintained labs with strict controls
- Focus on single embryo transfers to avoid complications
- Use of quality embryo tracking tools
- Personalised treatment—no copy-paste plans
- Calm, respectful staff that listens
- Honest consultation and cost clarity
- High success rates across age groups
- One of the top choices for blastocyst embryo transfer in Noida
FAQs on Blastocyst Culture Treatment
Yes, because the embryo is more developed, giving a better idea of which ones are stronger. That usually means higher success and fewer embryos needed.
Usually one or two. Doctors avoid transferring more to reduce the chance of twins or triplets.
Yes. It’s often used in repeat IVF cycles because it gives a clearer view of embryo quality and improves success.
No. Embryo transfer is done using a soft catheter. It may feel like a regular checkup—no pain or anesthesia needed.
Most women return to work the next day. Just avoid heavy lifting, stress, and long travel for a few days.




